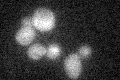
YNR074C
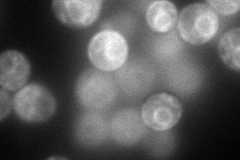
YNR074C
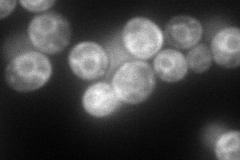
YNR074C
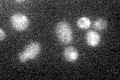
YNR074C

View description
Mitochondrial cell death effector that translocates to the nucleus in response to apoptotic stimuli, homolog of mammalian Apoptosis-Inducing Factor, putative reductase
Localization:
Intensity:
Fold change:
Significance:
-
C’ GFP library in SD
below threshold16.2 -
N' NOP1pr-GFP in SD
ER136.238 -
N' TEF2pr-mCherry in SD
ER152.465 -
N' NATIVEpr-GFP in SD

below threshold19.3359 -
N' TEF2pr-VC and Cyto-VN in SD

ER42.0238 -
C’ GFP library in SD+DTT

cytosol16.271No -
C’ GFP library in SD+H2O2

cytosol16.971.04No -
C’ GFP library in Starvation Media
cytosol28.271.74No -
C’ GFP library on the background of Pup2-DaMP

below threshold -
C’ GFP library on the background of CCT mutant

below threshold16.19160.998988No
